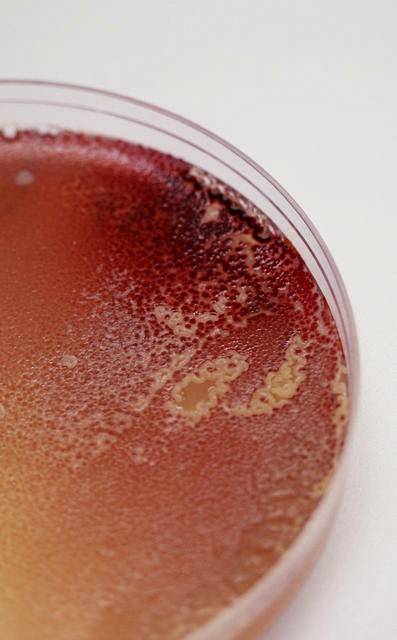

Maladies virales émergentes
Devons-nous craindre davantage les virus aujourd'hui?

Photo : Michel Caron
Qualifiée d’une des plus effrayantes depuis l’apparition de la maladie il y a 40 ans, l’épidémie d’Ebola qui sévit en Afrique de l’Ouest est causée par un virus émergent. Loin d’être disparues, les maladies infectieuses évoluent dans un environnement planétaire où la contagiosité est grandissante. Que doit-on apprendre des virus?
Les dernières années ont vu émerger la légionellose, la maladie de Lyme et de nouveaux types de virus herpès, notamment. La professeure Nancy Dumais s’intéresse quant à elle au VIH. «S’il est un virus qui brille au palmarès des maladies émergentes, c’est bien le VIH!» dit la virologiste et chercheuse du Département de biologie. Également chercheuse au Centre de recherche du CHUS, Nancy Dumais s’intéresse aux moyens de dissémination du VIH dans le corps humain. En 2012, elle a réalisé une découverte majeure avec son collègue Brendan Bell, de la Faculté de médecine et des sciences de la santé.
Ensemble, ils ont identifié les constituants cellulaires et viraux qui permettent d’activer spécifiquement le VIH. La communauté scientifique tentait depuis 20 ans de dénicher ces composants. Cette avancée a le potentiel de contrôler la latence du virus, pour en débarrasser l’organisme ou pour le rendre inactif. Une petite victoire sur un virus qui a fait de grands ravages ‒ plus de 36 millions de morts jusqu’à maintenant.
«Tant qu’il y a de la vie, il y a des virus, rappelle Nancy Dumais, pour qui la virologie est un terrain de recherche toujours renouvelé. Nous n’en viendrons jamais à bout, on a donc tout intérêt à apprendre d’eux.» Dans une conférence qu’elle prononcera ce dimanche, à la bibliothèque Éva-Senécal, Nancy Dumais propose une discussion sur les maladies virales émergentes. De quoi convaincre que la seule véritable arme dont dispose l’humain contre les virus est une meilleure connaissance de ces ennemis, aussi redoutables que minuscules.
Que nous apprend la flambée actuelle du virus Ebola en Afrique de l’Ouest?

C’est un des plus dangereux virus de la planète. La majorité des personnes infectées en décèdent. Ce virus a été découvert en 1976 et il sévit fortement dans les pays en voie de développement, où la malnutrition fait des ravages. Cette condition de vulnérabilité est parfaite pour les virus, qui se logent et se reproduisent à l’intérieur des cellules.
Dans ce cas-ci, le vecteur du virus est une chauve-souris – la roussette, une viande de brousse dont se nourrissent souvent les populations reculées, qui n’ont pas beaucoup d’autres choix. Le virus a été isolé et séquencé il y a quelques jours : il s’agit d’une souche émergente d’une espèce de virus déjà connue, Ebolavirus Zaïre. Malheureusement, contrairement à d’autres maladies virales, il n’y a pas de traitement antiviral pour Ebola. L’épidémie prendra quelque temps pour s’estomper, mais ce devrait être chose faite d’ici quelques semaines.
Il semble d’ailleurs que les technologies de l’information jouent un rôle dans le suivi de l’épidémie?
Oui, cette épidémie peut maintenant être suivie à la trace grâce à la contribution d’internautes volontaires. Les régions de Guinée qui sont les plus touchées ont été cartographiées, précisées par l’ajout d’informations reçues par des humanitaires et des internautes du service OpenStreetMap.
OpenStreetMap est un projet international démarré en 2004 pour créer une carte en accès libre, sur le web, de toute la planète. Les contributeurs ont bonifié les informations géographiques incomplètes ou floues qui apparaissaient sur les cartes. Ils ont localisé les différents cas de fièvre hémorragique en retraçant les contours de toute la région. Ces informations précieuses aident les soignants à se repérer sur le terrain et à suivre l’évolution de l’épidémie. Les nouvelles technologies de l’information, interactives, sont des outils précieux sur lesquels on peut heureusement compter aujourd’hui.
Qu’entend-on exactement par virus émergent, ou maladie émergente?
Ce sont des maladies causées par de nouveaux virus, ou des virus connus, mais qui réapparaissent sous de nouvelles formes. Le virus peut disparaître un certain temps et réapparaître des années plus tard, quand les conditions sont favorables, telles que l'évolution ou la modification d'un agent pathogène ou d'un parasite existant. Les causes peuvent être un changement d'hôte, de vecteur, de pathogénicité ou de souche. Le phénomène n’est pas récent, mais il aurait quadruplé au cours des 50 dernières années. En plus du VIH/SIDA, on peut penser au syndrome respiratoire aigu sévère (SRAS), au virus du Nil occidental, au virus Ebola et à H5N1.
Les virus de l’herpès ou de la varicelle ne font pas partie de cette classe; ce sont des virus avec lesquels nous vivons. Les virus de l’influenza, en revanche, sont considérés comme émergents, car de nouvelles formes apparaissent sur une base régulière.
Est-ce à dire que les virus sont aujourd’hui plus menaçants?
Il faut savoir que les virus ont toujours existé, depuis qu’il y a de la vie sur terre. Ils se reproduisent très rapidement, alors ils évoluent et s’adaptent aussi très vite. Est-ce qu’ils représentent aujourd’hui une menace plus grande? Pas particulièrement. On peut dire cependant que les relations entre humains et virus ont changé, parce que les relations entre les humains et leur environnement ont changé.
C’est-à-dire?
Par ses actions, l’humain simplifie, accélère, provoque ses contacts avec les réservoirs de virus et multiple les opportunités de transmission : l’accroissement continuel des constructions humaines, la culture et l’élevage intensifs, les manipulations de laboratoire, les changements climatiques, la déforestation, etc. Avec ces phénomènes on constate une augmentation des maladies émergentes avec les virus ayant besoin de réservoirs animaux ou de vecteurs, comme les insectes. D’autres phénomènes contribuent à disséminer ces nouvelles maladies : la promiscuité urbaine, l’intensification des transports, les mouvements de population, le matériel médical souillé, les relations sexuelles, etc.
Comment se défendre, aujourd’hui, des nouveaux virus?
Les connaissances et la rapidité de réaction contribuent à désamorcer les mouvements épidémiques. Une fois qu’un virus est isolé et identifié, on peut monter une défense immunitaire appropriée. La veille et la recherche sont aussi essentielles.
Par exemple, la communauté scientifique étudie maintenant de nouveaux virus, à mi-chemin entre la bactérie et le virus. Le mimivirus est le plus connu d’entre tous : il s’agit d’un virus géant, capable d’infecter un autre virus, chose que l’on ne croyait pas possible. Ce sont des virus marins, découverts un peu par hasard en 2003, et qui ne sont pas menaçants pour l’humain. Du moins pas pour l’instant! Mais s’ils le deviennent, nous aurons une longueur d’avance avec les données que les virologistes sont en train de recueillir.